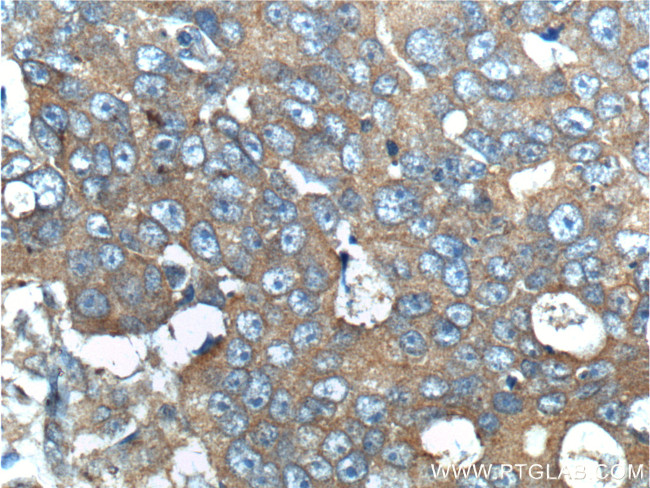
ERBB3 Antibody in Immunohistochemistry (Paraffin) (IHC (P))
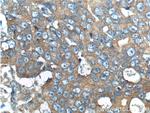
ERBB3 Antibody in Immunohistochemistry (Paraffin) (IHC (P))

Search
Proteintech
ERBB3 Polyclonal Antibody
{{$productOrderCtrl.translations['antibody.pdp.commerceCard.promotion.promotions']}}
{{$productOrderCtrl.translations['antibody.pdp.commerceCard.promotion.viewpromo']}}
{{$productOrderCtrl.translations['antibody.pdp.commerceCard.promotion.promocode']}}: {{promo.promoCode}} {{promo.promoTitle}} {{promo.promoDescription}}. {{$productOrderCtrl.translations['antibody.pdp.commerceCard.promotion.learnmore']}}
产品信息
10369-1-AP
种属反应
已发表种属
宿主/亚型
分类
类型
抗原
偶联物
形式
浓度
规格
纯化类型
保存液
内含物
保存条件
运输条件
产品详细信息
Immunogen sequence: LVAMNEFST LPLPNLRVVR GTQVYDGKFA IFVMLNYNTN SSHALRQLRL TQLTEILSGG VYIEKNDKLC HMDTIDWRDI VRDRDAEIVV KDNGRSCPPC HEVCKGRCWG PGSEDCQTLT KTICAPQCNG HCFGPNPNQC CHDECAGGCS GPQDTDCFAC RHFNDSGACV PRCPQPLVYN KLTFQLEPNP HTKYQYGGVC VASCPHNFVV DQTSCVRACP PDKMEVDKNG LKMCEPCGGL CPKAF (88-331 aa encoded by B C002706)
靶标信息
ErbB3 (c-erbB-3/HER-3) is a member of the type I family of growth factor receptors and binds to ligands in the heregulin family. ErbB3 is over-expressed in a variety of tumors in the prostate, bladder, breast, stomach, pancreas, and colon. Heregulin and EGF stimulate tyrosine phosphorylation of c-erbB-3 to different extents. The ErbB3 gene is located on the long arm of human chromosome 12 (12q13) and is transcribed into a 6. 2kb mRNA which is translated into a 160/180 kDa glycoprotein. The ErbB3 gene encodes a transmembrane receptor tyrosine kinase due to alternative splicing and forms heterodimers with other EGF receptor family members that have kinase activity. Heterodimerization leads to the activation of pathways that lead to cell proliferation or differentiation. Alternate transcriptional splice variants encoding different isoforms of ErbB3 have been characterized. One ErbB3 isoform lacks the intermembrane region, is secreted outside the cell, and acts to modulate the activity of the membrane-bound form. Additional splice variants have also been reported, but they have not been thoroughly characterized.
仅用于科研。不用于诊断过程。未经明确授权不得转售。
生物信息学
蛋白别名: C-errB-3; epidermal growth factor receptor precursor; HER3 protein precursor; human epidermal growth factor receptor 3; MDA BF 1; MGC88033; p180 ErbB3; p45 sErbB3; p85 sErbB3; Proto-oncogene-like protein c-ErbB-3; Receptor tyrosine-protein kinase erbB-3; Tyrosine kinase-type cell surface receptor HER3; unnamed protein product; v-erb-b2 avian erythroblastic leukemia viral oncogene homolog 3
基因别名: c-erbB-3; c-erbB3; ErbB-3; ERBB3; erbB3-S; FERLK; HER3; LCCS2; MDA-BF-1; p180-ErbB3; p45-sErbB3; p85-sErbB3; VSCN1
UniProt ID: (Human) P21860
Entrez Gene ID: (Human) 2065